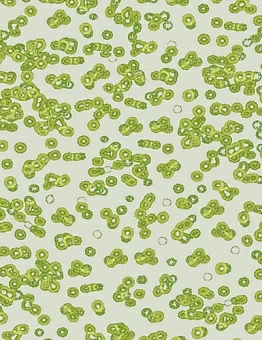
Ковролин Flotex Sottsass

Зеленый ковролин
Зеленый ковролин от ведущих европейских производителей приобретайте в магазине UnionMart. Мы предлагаем большой выбор ковровых покрытий в ярких и спокойных оттенках, с различным дизайном и высотой ворса. Продукция сертифицирована и реализуется по ценам изготовителя.
- 1
- 2
Зеленый ковролин в интерьере
Ковролин зеленого цвета уместен в современных и классических дизайнах. Он отлично вписывается в такие стили как минимализм, хайт-тек, кантри, модерн и другие. Зеленые оттенки сочетаются с белым, серым, бежевым, черным, коричневым и другими природными цветами.
Универсальность зеленого ковролина безгранична. Этот базовый цвет может использоваться в бытовых и коммерческих учреждениях, включая детские, медицинские, образовательные.
Купить зеленый ковролин от Unionmart
В каталоге товаров нашего магазина вы найдете ковровое покрытие с высокими эксплуатационными характеристиками. В наличии и под заказ множество коллекций ковролина, среди которых найдутся варианты в салатовых, ярко-зеленых, мятных, лаймовых, темно-зеленых и других оттенках
Преимущества ковролина от UnionMart:
- разнообразие ассортимента;
- доступные цены;
- сертификаты соответствия;
- высокий класс истираемости;
- долговечность;
- простота эксплуатации.
В каталоге представлен тафтингованный, иглопробивной и тканный ковролин в зеленом цвете из натурального и искусственного джута. Купить его можно от лучших в сегменте производителей – Ideal, Radici, Desso, ITC, Orotex, Forbo, Carus и других.
Наши преимущества






Наши клиенты